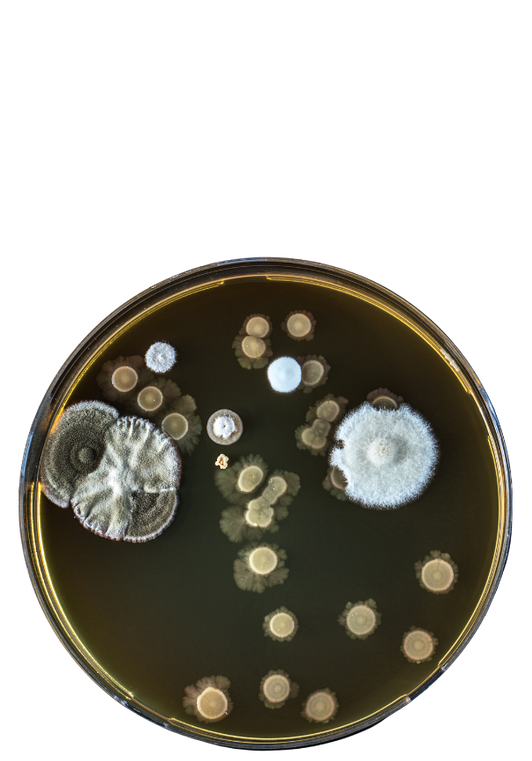

soluciones ecológicas para la
sanidad vegetal y la biodiversidad
control biológico de plagas
Protección natural contra plagas con biocontroladores como Torymus sinensis y Anaphes nitens. Eficiencia sin pesticidas para cultivos sostenibles.
proyectos de I+D+i
Nuestro departamento de I+D se dedica a desarrollar soluciones innovadoras en control biológico y promoción de la biodiversidad, garantizando prácticas agrícolas más sostenibles y respetuosas con el medio ambiente
asesoramiento, consultoría y formación
Expertos en sanidad vegetal y biodiversidad. Planes de manejo integrado de plagas (MIP) para agricultores, forestales y administraciones públicas.
productos
proyectos
asesoramiento
Descubre cómo podemos ayudarte según tus necesidades
ayuntamientos y administraciones públicas
Implementación de técnicas de control biológico para preservar el patrimonio natural
centro de investigación
Acceso a soluciones innovadoras desarrolladas en colaboración con proyectos de I+D+i
si eres empresa
Te ayudamos a reducir los costes a largo plazo con soluciones biológicas efectivas y sostenibles
si eres agricultor
Te asesoramos sobre cómo a hacer frente a plagas clave de forma sostenible
comprometidos con
el medio ambiente
comprometidos con
nuestros valores
descubre más sobre nosotros
Pulgón
(Aphididae)
Gonipterus scutellatus
Agallas de avispilla del castaño
(Dryocosmus kuriphilus)
Cochinilla algodonosa
Pseudococcidae
Helecho
Cyathea
Castaño europeo
(Castanea sativa)
(Coccinella septempunctata)
Avispilla del castaño
Dryocosmus kuriphilus
(Apis mellifera)
Contacta con nosotros para cualquier consulta
Fauna útil
Estr. A Guarda-Tui, Km. 194 – Forcadela
36730 · Tomiño. Pontevedra
699 227 053
info@faunautil.com